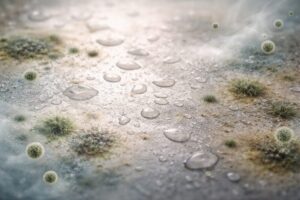

洗って再利用したり、分別のために乾かしたりするペットボトルですが、「なかなか乾かない…」「上向きと下向きどっちがいいの?」と迷う方も多いですよね。毎日のちょっとした家事だからこそ、手間を減らしてスムーズに終わらせたいと感じる方も多いのではないでしょうか。
ペットボトルは一見シンプルな形に見えますが、実は内部に湿気が残りやすい構造になっており、乾かし方によって乾燥スピードや衛生面に差が出ることがあります。見た目が乾いていても内側に水分が残っているケースもあり、知らないうちに乾燥不足になっていることも少なくありません。
また、乾かし方を間違えると、時間がかかるだけでなく、においや衛生面の不安につながる可能性もあります。特に再利用を考えている場合は、しっかり乾かすことが大切です。
この記事では、仕組みをもとにした乾かし方の考え方と、できるだけ効率よく乾かすためのコツを初心者の方にもわかりやすく解説します。日常生活ですぐに取り入れられる方法を中心に紹介しているので、今日から無理なく実践できます。
ペットボトルの乾かし方は上向き?下向き?【結論と理由】

結論:水切り後は「上向き」または「傾けた状態」が効率的
ペットボトルは、しっかり水を切ったあとに上向き、または少し傾けて通気を確保した状態で乾かすと効率的です。単に向きを変えるだけでなく、「空気の通り道をつくる」ことが乾燥スピードを左右します。
特に、口の部分がふさがれていない状態にすることが重要です。内部に新しい空気が入り、湿った空気が外へ抜ける流れができると、乾燥はぐっと進みやすくなります。逆に、空気の出入りが止まると、見た目は乾いていても内側に湿気が残ることがあります。
空気対流で乾く仕組み
ペットボトルの水分は、空気の入れ替わり(対流)によって蒸発していきます。内部の空気が温まったり、外の空気と入れ替わることで、水分は少しずつ気体になって外へ出ていきます。
このとき、空気がスムーズに出入りできる状態であれば、湿気が外へ逃げやすくなり、結果として乾燥が早まります。風通しのよい場所に置くと乾きやすいのも、この仕組みによるものです。
下向きが乾きにくい理由
下向きに置いた場合でも、完全に乾かないわけではありません。ただし、接地面が広くなってしまうと空気の通り道がふさがれやすく、内部の湿気が抜けにくくなることがあります。
また、置き方によっては口の部分がぴったりと接触してしまい、内部が密閉に近い状態になることもあります。このような場合、乾燥に時間がかかるだけでなく、湿気が残りやすくなるため注意が必要です。
45度前後がバランスよく乾きやすい理由(中間解)
ペットボトルを45度程度に傾けると、水を落としつつ空気の通り道も確保しやすくなります。水は自然に流れ落ち、同時に空気が入りやすくなるため、効率のよい乾燥状態を作りやすくなります。
この方法は、上向きと下向きの特徴をバランスよく取り入れた方法といえます。置き場所や道具によって調整しながら、少し角度をつけるだけでも乾きやすさが変わるため、ぜひ試してみてください。
ペットボトルが乾かない原因とは?【失敗パターン】

内部に水滴が残る理由
ペットボトルの内側は水が薄く広がって残りやすく、これが乾燥を遅らせる原因になります。特に、内壁にできる細かい水の膜は見えにくく、しっかり振って水を切ったつもりでも残っていることがあります。
また、表面に広がった水は点ではなく面で残るため、蒸発に時間がかかりやすいのも特徴です。こうした性質を理解しておくと、「なぜ乾かないのか」がイメージしやすくなります。
口が狭く空気が循環しない
開口部が小さいため、空気の出入りが制限され、乾燥しにくい構造です。空気がうまく入れ替わらないと、内部に湿った空気がとどまりやすくなります。
さらに、置き方によっては空気の通り道がふさがれてしまい、実質的に密閉に近い状態になることもあります。こうした状態では、乾燥に必要な空気の流れが生まれにくくなります。
湿度・気温の影響
湿度が高い環境では水分が蒸発しにくく、乾燥に時間がかかる傾向があります。空気中にすでに水分が多いと、それ以上水が蒸発しにくくなるためです。
また、気温が低いと蒸発のスピードも落ちるため、冬場や雨の日は特に乾きにくさを感じやすくなります。季節によって乾燥時間が変わるのは、この影響によるものです。
置き場所の問題(通気性)
風通しが悪い場所では湿気がこもりやすく、乾燥効率が下がります。例えば、壁にぴったりつけて置いたり、他の食器と密着させて置いたりすると、空気の流れが妨げられます。
空気が動く場所に置くだけでも、乾燥スピードは大きく変わります。キッチンでも、少し位置を変えるだけで違いを感じることがあります。
水切り不足の落とし穴
水を十分に切らないまま乾かすと、乾燥時間が大きく延びることがあります。中に残る水の量が多いほど、蒸発にかかる時間も長くなります。
最初のひと手間としてしっかり振って水を切るだけでも、その後の乾きやすさに差が出ます。乾燥を早めたい場合は、この工程がとても重要です。
上向き・下向きの乾燥時間と衛生面の違い

乾燥スピードの違い
通気が確保されている場合、上向きや傾けた状態のほうが乾燥が進みやすい傾向があります。空気が出入りしやすく、湿気が外に逃げやすくなるためです。
一方で、通気が確保されていない置き方では、どちらの向きでも乾燥に時間がかかることがあります。向きだけでなく、空気の流れを意識することがポイントです。
湿気のこもり方の違い
通気が不十分な状態では、内部に湿気が残りやすくなります。特に下向きで接地している場合は、湿った空気が抜けにくくなることがあります。
湿気がこもると、見た目が乾いていても内部が完全に乾いていない状態になりやすい点に注意が必要です。
カビ・雑菌リスクの違い
水分が残る状態が続くと、一般的に微生物が増えやすい環境になると考えられています。湿気と温度がそろうと、微生物が活動しやすい環境になるためです。
しっかり乾かすことは、こうしたリスクを抑えるための基本的な対策のひとつといえます。
臭い発生リスクの違い
湿った状態が続くことで、においが発生することがあります。これは水分と微生物の影響によるものと考えられます。
一度においが出てしまうと取りにくい場合もあるため、日頃からしっかり乾燥させておくことが大切です。
【比較表】上向きと下向きどちらが優れている?

| 比較項目 | 上向き・傾けた状態 | 下向き(接地あり) |
|---|---|---|
| 乾燥スピード | 早い(空気が入りやすい) | 遅い(湿気がこもりやすい) |
| 湿気の抜けやすさ | 抜けやすい | 抜けにくい |
| 衛生面 | 安定して清潔を保ちやすい | 状態によっては湿気が残る |
| におい発生 | 起こりにくい | 起こる可能性あり |
| おすすめ用途 | 再利用・衛生重視 | 一時的な水切りのみ |
乾燥速度・衛生・安全性の比較
通気がある上向き・傾けた状態は乾燥が進みやすく、通気のない下向きは乾燥が遅れやすい傾向があります。
ただし、これは「置き方」によって大きく変わる点にも注意が必要です。例えば、下向きでも空間が確保されていれば乾くこともありますが、接地してしまうと乾きにくくなります。
また、乾燥速度だけでなく、内部に湿気が残りにくいかどうかという点でも差が出ます。通気がある状態のほうが、より安定して乾燥しやすいと考えられます。
用途別おすすめ(再利用・分別など)
再利用や衛生面を重視する場合は、通気を確保した乾かし方が適しています。特に飲み物を再度入れる場合は、内部の乾燥状態が重要になります。
一方で、分別のために乾かすだけであれば、ある程度水分が抜けていれば問題ない場合もあります。ただし、自治体によってルールが異なるため、できるだけしっかり乾かしておくと安心です。
ペットボトルを最速で乾かす方法【時短テクまとめ】

正しい水切り(振る・叩く)
洗ったあとにしっかり振ることで、水滴を減らし乾燥時間を短縮できます。特に、上下に大きく振ることで内部の水を外に出しやすくなります。
また、軽く振るだけでなく、数回繰り返すことで残りやすい水滴も落としやすくなります。このひと手間が、その後の乾きやすさに大きく影響します。
45度で乾かすテクニック
傾けることで水と空気の流れを確保できます。完全に上向きにするよりも、水がたまりにくくなるメリットもあります。
設置面を少なくすることで空気が通りやすくなり、自然と乾燥しやすい状態を作ることができます。
お湯すすぎで乾燥が早くなる理由
温かい水は冷たい水よりも蒸発しやすい性質があり、条件によっては乾燥がやや進みやすくなることがあります。
さらに、温度が少し高い状態から乾かし始めることで、最初の蒸発スピードが上がるため、結果的に乾燥時間の短縮につながります。
風を当てると効果的な理由
空気の流れがあると水分が外へ運ばれやすくなります。自然な風でも効果がありますが、扇風機や換気を活用するとより効率的です。
風によって湿気が外へ逃げるため、内部の空気が入れ替わりやすくなります。
振ると乾きが早くなる仕組み
水滴の量を減らすことで、蒸発する量を減らせます。乾燥は「残っている水の量」に大きく左右されるため、最初にどれだけ水を減らせるかが重要です。
細かい水滴まで落としておくことで、乾燥のスタート地点を大きく変えることができます。
乾燥時間の目安(何時間で乾く?)
環境によって異なりますが、数時間〜半日程度が目安となることが多いです。
ただし、湿度が高い日や風通しが悪い場所では、さらに時間がかかることもあります。逆に、風があり乾燥した環境では、想像よりも早く乾くこともあります。
100均・家にあるものでできる乾燥アイデア

割り箸・菜箸を使う方法
口に差し込むことで通気性を確保できます。ボトルの口を完全にふさがないように軽く差し込むのがポイントで、隙間をつくることで空気が出入りしやすくなります。
また、2本使って「ハの字」にすると安定しやすく、倒れにくくなるためおすすめです。シンプルですが効果が出やすい方法です。
キッチン用品で代用する
ラックや水切りカゴなどを使うことで空気が通りやすくなります。底面が網状のものを選ぶと、接地面が減って通気性がさらに高まります。
コップスタンドやボトルスタンドがあれば理想的ですが、普段使っているキッチン用品でも十分代用可能です。置き方を少し工夫するだけで乾きやすさが変わります。
逆さに固定する工夫
接地面を減らし、通気を確保することがポイントです。例えば、ボトルの口が直接台に触れないように、隙間をつくるだけでも効果があります。
完全に密着させるのではなく、「少し浮かせる」ことを意識すると、内部の湿気が抜けやすくなります。
キッチンペーパー・ティッシュはあり?
軽く水分を吸わせる程度であれば使えますが、詰め込みすぎると逆に乾きにくくなることがあります。
特に奥まで押し込むと通気を妨げてしまうため、あくまで一時的な水分吸収として使うのが安心です。取り忘れにも注意しましょう。
専用グッズなしで乾かすコツ
通気と水切りを意識すれば、特別な道具がなくても乾かしやすくなります。重要なのは「空気の流れ」と「水の量を減らすこと」です。
少し傾ける、風が当たる場所に置くなど、身近な工夫を積み重ねることで、乾燥効率はしっかり高められます。
乾かす環境で差が出る!場所・季節別のコツ

室内で乾かす場合
風通しのよい場所を選ぶことで乾燥しやすくなります。窓の近くや換気扇の近くなど、空気が動いている場所を選ぶのがポイントです。
同じ室内でも、置き場所によって乾きやすさは大きく変わります。
キッチン・水回りで乾かす場合
湿気が多い場所では換気を意識することが大切です。調理中や洗い物の後は湿度が上がりやすいため、換気扇を回すなどの工夫が効果的です。
水回りは便利ですが、環境によっては乾きにくいこともあるため注意が必要です。
梅雨・冬の湿度対策
除湿や空気の入れ替えを行うことで乾燥しやすくなります。除湿機やエアコンのドライ機能を活用すると、より効果的です。
湿度が高い時期は乾燥に時間がかかりやすいため、少し環境を整えるだけでも差が出ます。
夏の乾きやすい条件
気温が高く湿度が低い環境では乾燥が進みやすい傾向があります。特に風がある日は、自然乾燥でも比較的早く乾きます。
ただし、直射日光で高温になりすぎる場合は、変形などに注意が必要です。
急いで乾かす場合の最適環境
風と適度な温度を組み合わせると効率的です。扇風機やサーキュレーターで風を当てると、乾燥スピードが上がります。
さらに、温かい状態から乾かすことで蒸発が進みやすくなるため、「風+温度」を意識するとより効果的です。
やってはいけないNGな乾かし方

密閉状態で放置する
湿気がこもり、乾燥が進みにくくなります。特に、口の部分がふさがれている状態では内部の空気が入れ替わらず、見た目よりも乾いていないケースが多くなります。
また、湿気がこもった状態が続くと、においや衛生面のトラブルにつながる可能性もあるため注意が必要です。
濡れたまま重ねる
通気が悪くなり乾燥が遅れる原因になります。複数のペットボトルをまとめて置くと、空気の通り道がなくなり、湿気が逃げにくくなります。
特に底や側面が密着していると乾燥しにくくなるため、できるだけ間隔をあけて置くことが大切です。
通気性の悪い場所に置く
空気が流れない場所では乾きにくくなります。例えば、壁際や棚の奥などは風が通りにくく、湿気がこもりやすい環境です。
少し位置を変えて風通しのよい場所に置くだけでも、乾燥スピードは大きく変わります。
下向き固定しすぎる
通気が確保されないと乾燥効率が下がります。口の部分が完全に接地してしまうと、内部の空気が動かなくなり、乾燥が進みにくくなります。
下向きにする場合でも、隙間をつくるなどして空気の通り道を確保することがポイントです。
乾く前にキャップを閉める
内部に湿気が残る原因になります。一見乾いているように見えても、内部にはまだ水分が残っていることがあるため注意が必要です。
キャップを閉めるのは、完全に乾いたことを確認してからにすることで、においや雑菌の発生を防ぎやすくなります。
乾燥不足で起こるトラブルとリスク

カビが発生する条件
湿度と温度などの条件がそろうと、一般的にカビが発生しやすい環境になるとされています。特に、湿った状態が長時間続くと、カビが発生しやすい状態になる可能性があります。
日常的に使用する場合は、こうした条件を避けるためにも、しっかり乾燥させることが大切です。
臭いが残る原因
水分と微生物の影響でにおいが発生することがあります。乾ききっていない状態では、内部に残った水分がにおいの原因になることがあります。
一度においがつくと落としにくい場合もあるため、日頃からしっかり乾かすことが重要です。
雑菌増殖の仕組み
水分が残ることで雑菌が増えやすくなる可能性があります。湿気のある環境は、微生物にとって活動しやすい状態になるためです。
乾燥させることは、こうしたリスクを抑えるための基本的な対策のひとつです。
衛生面で注意すべきポイント
完全に乾いた状態を確認してから使用することが大切です。見た目だけで判断せず、内部までしっかり乾いているかを意識しましょう。
再利用する場合は特に、乾燥状態を確認する習慣をつけることで、より安心して使うことができます。
ペットボトルの再利用は安全?知っておきたい基礎知識
基本は使い切りが推奨される理由
衛生面の観点から、一般的には使い切りが推奨されています。ペットボトルは軽くて扱いやすい反面、繰り返し使用することで細かい傷がつくことがあり、その部分に汚れや微生物が付着しやすくなる可能性があります。
さらに、飲み口は直接口に触れるため、使用後は見えない汚れが残っていることもあります。こうした理由から、多くのメーカーでは衛生面を考慮し、基本的には使い切りを前提とした利用が推奨されています。
再利用時のリスク
洗浄や乾燥が不十分な場合、衛生面のリスクが高まる可能性があります。特に水分が残っていると、微生物が増えやすい環境になる可能性があり、においやぬめりの原因になることがあります。
また、糖分を含む飲料(ジュースやスポーツドリンクなど)を入れていた場合は、成分が内部に残りやすく、しっかり洗浄しないと衛生面の不安が残ることがあります。
安全に使うための目安
清潔な状態を保ち、長期間の繰り返し使用は避けることが安心です。再利用する場合は、その日のうちに使い切る、しっかり洗って完全に乾燥させるなど、基本的な衛生管理を意識しましょう。
また、においや変形、キズが目立ってきた場合は無理に使い続けず、新しいものに交換することが大切です。
避けたほうがいい使い方
長期間の使用や不衛生な状態での利用は控えるようにしましょう。例えば、洗わずに繰り返し使う、湿ったままフタを閉めて保管する、といった使い方はトラブルの原因になりやすいです。
特に気温が高い季節は雑菌が増えやすいため、再利用する場合でもより丁寧な管理が求められます。
上向き乾燥がおすすめな人・シーン

子どもの飲み物用に使う場合
衛生面を意識したい場合は通気を確保した乾燥方法が安心です。特に小さなお子さんが使う場合は、見えない汚れや水分が残らないよう、しっかり乾燥させることが大切です。
毎日使うものだからこそ、乾きやすい環境を整えておくと安心して使い続けられます。
スポーツドリンク使用時
成分が残りやすいため、しっかり乾燥させることが重要です。糖分やミネラル分が内部に残ると、においやベタつきの原因になることがあります。
洗浄後は特に念入りに乾燥させることで、清潔な状態を保ちやすくなります。
衛生面を重視したい人
乾きやすさを優先することで清潔に保ちやすくなります。日常的に再利用する方や、におい・ぬめりが気になる方は、通気性のよい乾かし方を取り入れるのがおすすめです。
乾燥しやすい置き方を習慣化するだけでも、衛生面の安心感が大きく変わります。
分別前にしっかり乾かしたい人
水分を残さないことで扱いやすくなります。分別やリサイクルの際に水が残っていると、手間が増えたり不衛生に感じることもあります。
しっかり乾かしておくことで、処理もしやすくなり、日々の家事の負担軽減にもつながります。
ペットボトル乾燥のよくある質問(Q&A)

キャップは外すべき?
外して乾かすことで通気性が良くなり、内部の湿気が抜けやすくなります。キャップを付けたままだと空気の出入りが制限され、見た目よりも乾いていない状態になりやすい点に注意が必要です。
また、キャップ自体にも水分が残ることがあるため、ボトル本体とは別に乾かしておくとより安心です。完全に乾いたことを確認してから閉める習慣をつけると、においや衛生面のトラブルを防ぎやすくなります。
日光で乾かしていい?
乾燥には役立ちますが、直射日光で高温になると変形や劣化の原因になる可能性があるため、長時間の放置は避けると安心です。特に夏場はボトル内部の温度が上がりやすく、思った以上に負担がかかることがあります。
日光を使う場合は、短時間にとどめるか、風通しのよい日陰を活用するなど、温度が上がりすぎない工夫をするとより安全です。
ドライヤーは使える?
短時間・低温(冷風が理想)であれば使用できますが、温風を長時間当てると変形や劣化の原因になる可能性があるため注意しましょう。特にボトルの口元や薄い部分は熱の影響を受けやすいです。
急いで乾かしたい場合は、ドライヤーよりも風を当てる(扇風機など)ほうが安全で安定した方法といえます。
どのくらいで乾く?
環境によって異なりますが、数時間〜半日程度が目安です。風通しがよく乾燥した環境であれば、数時間で乾くこともあります。
一方で、湿度が高い日や風がない場所では、半日以上かかることもあるため、環境による差を意識しておくと安心です。
おすすめの置き方は?
上向き、または少し傾けて通気を確保する置き方がおすすめです。特に45度程度に傾けると、水が抜けやすく空気の流れも作りやすいため、効率よく乾かせます。
また、口の部分が接地しないように工夫すると、さらに乾燥しやすくなります。ちょっとした置き方の違いが、乾きやすさに大きく影響します。
まとめ|ペットボトルは「乾かし方」で清潔さと時短が変わる

ペットボトルは乾かし方によって、乾燥時間や衛生状態に差が出ます。同じように洗っていても、置き方や環境によって乾き方が変わるため、正しい方法を知っておくことが大切です。
大切なのはしっかり水を切り、空気の流れを作ることです。最初の水切りを丁寧に行い、通気性を意識した置き方をするだけで、乾燥効率は大きく変わります。
上向きや傾けた状態をうまく活用しながら、風通しのよい場所を選ぶことで、より効率的に清潔な状態を保ちやすくなります。日々のちょっとした工夫の積み重ねが、時短と安心につながります。


